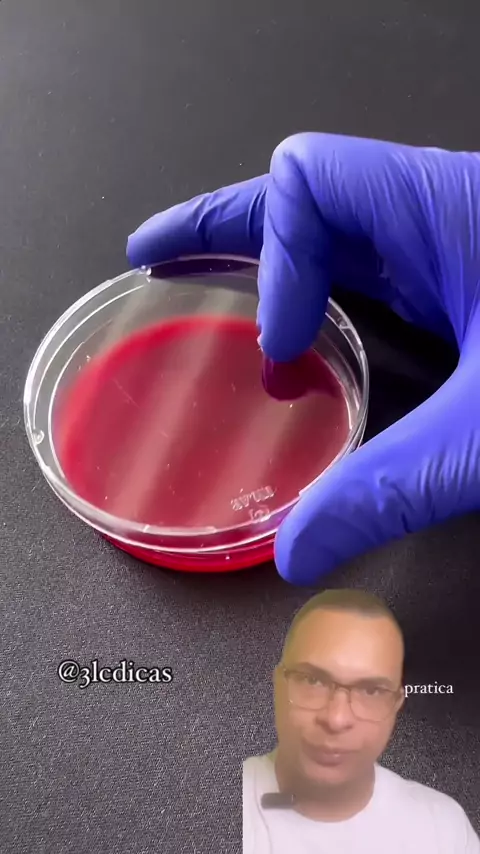

3lcdicas

292
Posts

All playlists · Total 13

2
Cimento seco! Isso mesmo! Lá na Turquia eles usam cimento em pedaços secos para ser aplicado nas obras e reformas! Ao molhar o cimento ele permite que seja feita a junção entre os tijolos e ao secar fica muito sólido e faz seu papel! . Siga @3lcdicas . #cimento #cimentoqueimado #tiposdecimento #cimentoportland #comofazercamarao

2
CLIQUE NO BOTÃO SEGUIR 👆👆👆 Você consegue explicar como um ovo desapareceu?! . Siga @3lcdicas . #mágica #magiamadokamagica #truquedemagica #magician #tutorialdemagica

2
LIQUE NO BOTÃO SEGUIR 👆👆👆 Olha só isso!!! . Siga @3lcdicas . #comédia #comédiasertão #videosdecomédia #comédiabrasileira #comédiasempalavrão

3
Deixe a tampa do vaso fechada sempre! É isso que acontece quando você dá descarga com ela levantada. . Siga @3lcdicas . #bactérias #vasosanitário #bacterias #águasanitária #sanitarios

2
Essa eu demorei mais de 4 décadas para aprender. . Siga @3lcdicas . #touca #toucaemtnt #toucatnt #comofazertouca #máquinatoucatnt

2
Você teria coragem de colocar dinheiro na sua capinha transparente do celular e andar com ele pela rua falando com alguém? 💸💵 . Siga @3lcdicas . #capacelular #capaparacelular #capinhaparacelular #capapracelular #capinhacelular

2
Eu duvido que você sabia que a forma correta de usar esse descascador de legumes é assim! . Siga @3lcdicas . #descascadordelegumes #descascadordelegumesefrutas #comodescascarmandiocacomdescascadordelegumes #mandiocacomcarnedesol

2
Faça você mesmo uma toca para seu gato usando uma caixa de papelão e uma camisa velha! 🐈🐱 . Siga @3lcdicas . #tocaparagato #tocaparagatos #tocadegato #toca #gatos

4
Você sabia que guardar o bolo na tampa é muito melhor e facilita na hora de servir?!!! 😍 🥮 . Siga @3lcimports . #bolodeandar #comoguardarafarinhadeformacerta #bolo #receitadebolo #bolodefesta

2
Esquente a tampa do óleo, coloque um palito e depois que esfriar corte a ponte. Você terá um dosador de óleo, irá consumir menos gordura e evitar desperdício! 🤩 . Siga @3lcimports . #comofazerumdosadordeóleo #comofazerumdosadordeóleodecozinha.comenteoqueachou #comofazerumcocodechocolate

2
☕✨ Café com Laranja! Experimente e eu lhe garanto que você irá se surpreender! 🍊 Se você é amente de café, assim como eu, experimente colocar uma rodela de laranja no coador que você não irá se arrepender. Esse café com um leve sabor cítrico será uma experiencia única ao seu paladar! Compartilha com aquele amigo seu que também é amante de café! Comenta aqui o que você achou dessa dica! . Siga @3lcimports . #cafe #CafeGoumet #brunch #jejum

4
Passe álcool em gel um uma toalha e coloque em volta do pescoço que o alívio será imediato! 😷 🤧 . Siga @3lcimports . #dica #dicas #donadecasa #casa #familia

4
Eu duvido que você sabia que dentro da semente do avocado tem poupa! 😱🥑 . Siga @3lcimports . #dica #dicas #abacate #avocado #avocado